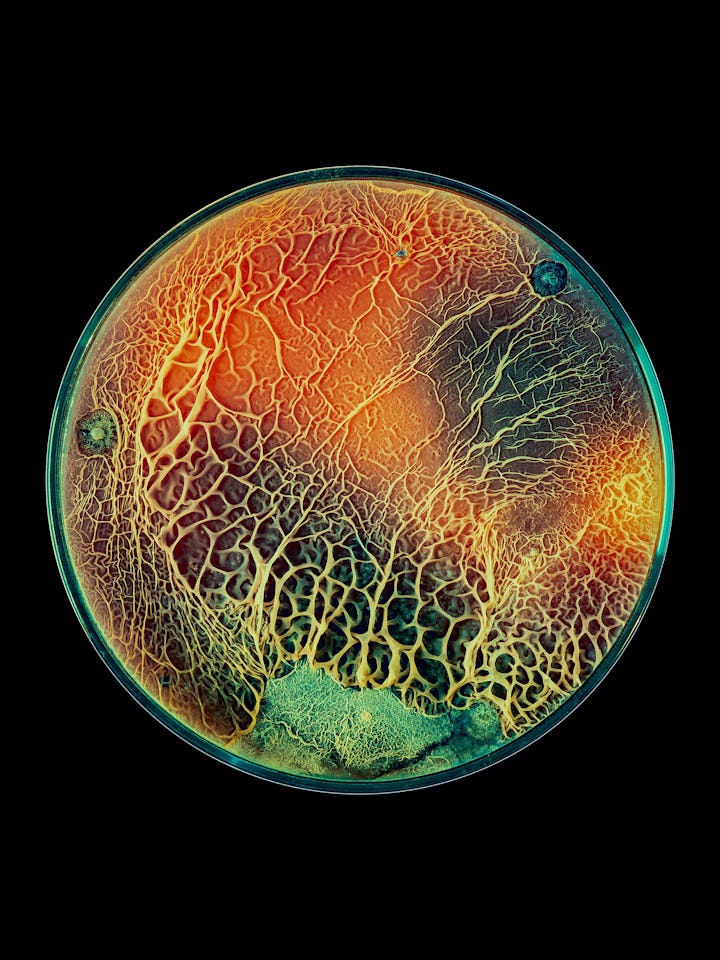

Inside the Race To Create the World’s First Anti-Fungal Vaccine
As climate change shifts where fungi live and how it functions, researchers are racing to create new therapies to stay ahead of the game.
In late 2022, the World Health Organization released a list of 19 fungi that pose the greatest threat to public health. When we think about dangerous infectious diseases, drug-resistant bacteria or deadly viruses like SARS-Cov-2 often come to mind. But in the coming years, scientists will need to be increasingly concerned about another potentially deadly group of pathogens: Fungi.
“The biggest challenge with treating systemic fungal infections right now is the fact that we only have three major classes of antifungal drugs, compared to several dozen classes of antibacterials,” Leah Cowen, a professor of molecular genetics at the University of Toronto, tells Inverse.
Climate change is expected to heat the planet and shift weather patterns, altering not only where we can live but where other species can thrive, too. The shift in temperature will alter where different species of fungi live –– and potentially make it easier for some to survive in the human body. In fact, climbing temperatures are the most immediate factor influencing the rise in fungal infections.
In the U.S. alone, the number of drug-resistant cases of Candida auris tripled in 2021.
Already, in the U.S. alone, the number of drug-resistant cases of Candida auris, a yeast that typically poses a threat to immunocompromised people, tripled in 2021. Coccidioides, a fungus that thrives in the hot, dry soil of the United States southwest and parts of Mexico and South America, also caught the agency’s attention.
Unfortunately, most fungi are not well-monitored or understood, and fungal infections are already notoriously difficult to treat. Now, scientists are racing to study fungi better and create new treatments. There are a number of new antifungals in the works, but there is also a growing number of researchers working on vaccines to prevent the deadliest of fungal infections. If one of them pans out, it would be the first vaccine to prevent a fungal infection.
Rising Temperatures
People can only get sick from fungi that can grow at body temperature, and most environmental fungi humans ingest haven’t adapted to do so.
“Right now, our high body temperature has been serving as a thermal barrier to most infection from environmental fungi, the ones we breathe in as spores in the air,” Asiya Gusa, a mycologist in the Department of Molecular Genetics and Microbiology at the Duke University School of Medicine, tells Inverse.
Most fungi are not well-monitored or understood, and fungal infections are already notoriously difficult to treat.
Gusa is part of a team of researchers exploring how climbing temperatures will affect the fungal genome. In a lab study published earlier this year in PNAS, they compared how a type of fungus called Cryptococcus deneoformans evolved at around 86 degrees Fahrenheit compared to how it evolved at human body temperature –– an increase of about 10 degrees Fahrenheit.
After 100 days of growth, or about 800 generations of offspring, higher temperatures seemed to pressure the fungi to increase the number of mutations that showed up in each new generation. As the planet heats up, it’s possible that this super-charged rate of mutation could help fungi adopt new traits that would help them infect hosts or resist drug treatment.
Disease-causing fungi might evolve more quickly than researchers anticipated.
“That concerned us because we now have more heat stress in the environment and fungi that aren’t normally seeing higher temperatures,” says Gusa. “That puts pressure on them to adapt to be able to grow at those higher temperatures.” If heat stress does act as a trigger that increases mutations, disease-causing fungi might evolve more quickly than researchers anticipated, she says.
Are new fungal vaccines coming to save us?
Currently, no vaccines to prevent fungal infections exist. That’s partly due to a lack of funding interest from pharmaceutical companies. But it’s also due to the nature of fungi themselves and those who are most vulnerable to severe fungal infections.
Fungi — which include yeasts, mildews, molds, rusts, smuts, and mushrooms — are eukaryotic organisms, the same class as human cells. This means fungal infections are notoriously difficult to treat: Designing therapies that target fungal cells but leave the body’s native cells alone is much harder than creating treatments for bacteria and viruses, which are very different from human cells.
In the vaccine world, targets refer to the unique part of an organism that prompts a person’s immune system to produce antibodies that recognize and attack any intruder carrying it.
Compared to viruses, fungi have more potential targets, Karen Norris, a professor at the University of Georgia’s Center for Vaccines and Immunology, tells Inverse. “To identify those, you have to really understand the fungi,” she says.
Ideally, a fungal vaccine would protect against multiple types of fungi — so Norris and her team have made huge strides to make this happen. They’ve identified a single target that’s shared among three of the most common fungi responsible for deadly human infections: Aspergillus, a mold that invades the lungs and sinuses; Candida (specifically C. auris), a yeast that can cause serious blood infections; and Pneumocystis, which causes pneumonia.
Candida (specifically C. auris, pictured above) is a yeast strain that can cause serious blood infections.
Their pan-fungal vaccine hasn’t entered human clinical trials yet, but it showed promise in animal trials. The vaccine even prompted an immune response in immunocompromised animals.
A necessary next step is to get funding for clinical trials, which would likely come from a private pharmaceutical company with the resources to develop doses of the vaccine. Fortunately, the pan-fungal vaccine uses the same peptide technology that’s been used in immunizations for decades.
Still, planning the trial will be difficult. Fungal infections don’t affect just one type of patient, says Norris, which makes figuring out who to include in human vaccine trials a bit trickier.
“If you had one infection in one population, that would be a very straightforward trial to design,” she says.
Some single-target fungal vaccines are also in the works, which could prove a bit easier to create. Researchers at the University of Arizona and the University of Kansas are close to developing a human vaccine for Valley Fever, which is caused by the fungus Coccidioides.
In recent years, scientists have mapped how climate change has expanded Coccidioides’ territory. Because shifts in climate are prompting extended drought in once humid ecosystems, the fungi are now found as far north as Washington state.
On a global scale, Valley Fever only impacts a very small number of people, but locally, it’s a major public health concern, John Galgiani, director of the Valley Fever Center for Excellence at The University of Arizona College of Medicine in Tucson, tells Inverse.
People breathe in Coccidioides all the time, and most of the time, it doesn’t cause problems. But it can take months to treat when it does. In some, it can be deadly. And like Covid-19, it disproportionately affects BIPOC, elderly, and imprisoned communities.
“The economic impact is thought to be $1.5 billion, and that’s before climate change,” Galgiani says.
Another major hurdle looms
Right now, all potential antifungal drugs focus on the same molecular targets as those in the works for use in medicine and agriculture. These parallel uses may put pressure on fungi to resist certain antifungals. The same phenomenon has already gone down with other antifungal drugs.
That’s the case with olorofim, an antifungal drug currently in clinical trials, and ipflufenoquin, an antifungal made for fruit and almond trees that’s pending approval from the Environmental Protection Agency. The antifungals have the same target, so ipflufenoquin could dampen olorofim’s efficacy in humans if it gets approved first — a high-stakes scientific race.
The use of azoles, a class of antifungals that includes fluconazole, in agriculture has driven drug resistance in a mold called Aspergillus fumigatus, which commonly causes infections in immunocompromised patients.
The use of azoles, a class of antifungals that includes fluconazole, in agriculture has driven drug resistance in a mold called Aspergillus fumigatus, which commonly causes infections in immunocompromised patients — but scientists had hoped to protect against it with the pan-fungal vaccine. This microbe lives all over the natural world, so scientists think it likely encountered the antifungals used in agriculture.
Ultimately, it’ll probably take less time to create new drugs based on existing antifungals than to churn out new types of vaccines. But moving forward in a warming world, we’ll probably need both tools in the antifungal arsenal.
“We all recognize there is a need,” Norris says. “There are 1.5 million people a year around the world that die of invasive fungal infections — that’s enormous.”